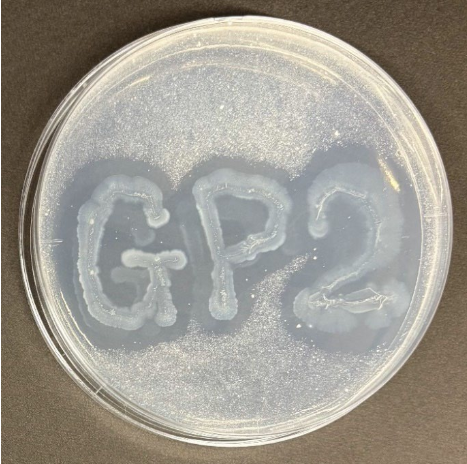

アーカイブ情報
2025/2/26
【生分解性プラの分解】慶応大、カネカの Green Planet を数日で完全分解する微生物を発見
慶應義塾大学理工学部の山本果緒氏(生命情報学科4年)、慶應義塾先端科学技術研究センター研究員の黄穎氏、同大学理工学部教授の宮本憲二氏の研究グループは、カネカが工業生産している生分解性プラスチック(Green Planet 以下 GP)をわずか数日で完全分解する微生物の取得に成功した。
GP は、他の生分解性プラスチックと比較して高い生分解性を示すものの分解に時間がかかるため、高速に分解する技術が求められていた。この成果は、GP の分解時間を大幅に短縮するものであり、使用済みの GP 製品のオンサイトでの分解処理を実現する上で重要な一歩となる。この成果は、2025 年 3 月 8 日の日本農芸化学会で発表される。
研究の背景
近年、環境へのプラスチックの流出と蓄積が大きな社会問題となっている。石油を原料として合成されたプラスチック(例えばポリエチレン:PE やポリプロピレン:PP 等)は、自然界での微生物分解が非常に困難である。そのため、自然界で微生物によって分解できる生分解性プラスチックが関心を集めている。その中でも、カネカが開発した GP は、100%バイオマスから微生物によって作られる生分解性プラスチックとして注目されている。GP は、土中のみならず海水中においても高い生分解性を示すことから、海洋マイクロプラスチック問題の解決をはじめ、地球環境保全に貢献すると期待されている。最近では、GP を用いたストローが、日本国内のスターバックス店舗で採用されたことでも話題になった。しかし、環境中での GP ストローの分解には、数週間から数カ月程度は必要であるため、高速に分解する手法が望まれていた。
研究の内容・成果
同研究グループは株式会社カネカの協力の下、兵庫県高砂市のカネカ高砂工業所内の GP生産プラント周辺の環境サンプルから GP 分解菌の探索を行った。GP パウダーを含む寒天プレートに分離した候補株を塗布したところ、いくつかの候補株のコロニーの周りに明瞭なハローを確認した。。ハローを作った微生物は、GP を分解する酵素を細胞の外へ出していると考えられる。
ハローを確認できた候補株について、GP フィルムを用いた評価を行ったところ、GP-2株が最も高い分解率を示しました。GP-2 株は、GP フィルムを 3 日で約 100%の分解率を示した。また、フィルムより厚いストローは、約 2 週間で完全に分解しました。GP-2は同定検査の結果、Acidovorax 属の微生物であることが分かった。

今後の展開
GP 製品をわずか数日で分解する微生物を発見しました。従来の環境下での分解速度と比較すると圧倒的に高速であり、使用した店舗などでのオンサイト分解処理に繋がる画期的な成果であると考えられる。今後は、さらに解析や条件の最適化を進めて、社会実装を目指して研究を進めていく考えだ。
「学会発表情報」
第日本農芸化学会 2025 年度大会、3 月 8 日、札幌コンベンションセンター
演題: PHBH 分解菌の探索と分解能評価
演者:山本 果緒、黄 穎、宮本 憲二
「研究費」
同研究は、JST 共創の場形成支援プログラム(COI-NEXT)JPMJPF2111 の支援により行われた。
- カテゴリー
- コンバーティングニュース

